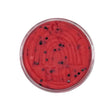
KidDough | Watermelon Slice showing red dough with black glitter seeds in a clear container.

KidDough | Watermelon Slice
Couldn't load pickup availability
Would it even be summer without Watermelon? This dough features chunky black glitter seeds and smells so good you'll think you're at a picnic! Includes One Half Pound KidDough in: Watermelon Slice with Black Glitter Seeds.
These super silky sensory doughs model like playdough, but are softer, more pliable, and far longer lasting! Every all-natural KidDough is made with non-toxic food grade ingredients and is totally taste safe. These super durable doughs last for hundreds of hours of play (12 months on average) but wash out easily with just warm water. If ever you experience drying, just knead to rehydrate! Kids love our extra-large east open containers. KidDoughs also contain essential oils to help control germs during play and can be fully heat sanitized in the microwave. Ingredients: Wheat Flour, Salt, Canola Oil, Cream of Tartar, Water, Food Coloring, Organic Potassium Sorbate, and Natural Fragrance.
Shipping Information
Shipping Information
📪️ All shipping orders are sent from Portland. Items must be available in the Portland store in order to process a shipping order.
📪️ We ship via UPS
📪️ Orders are processed daily, and picked up for transit Monday-Friday
📪️ Flat Rate $9.95